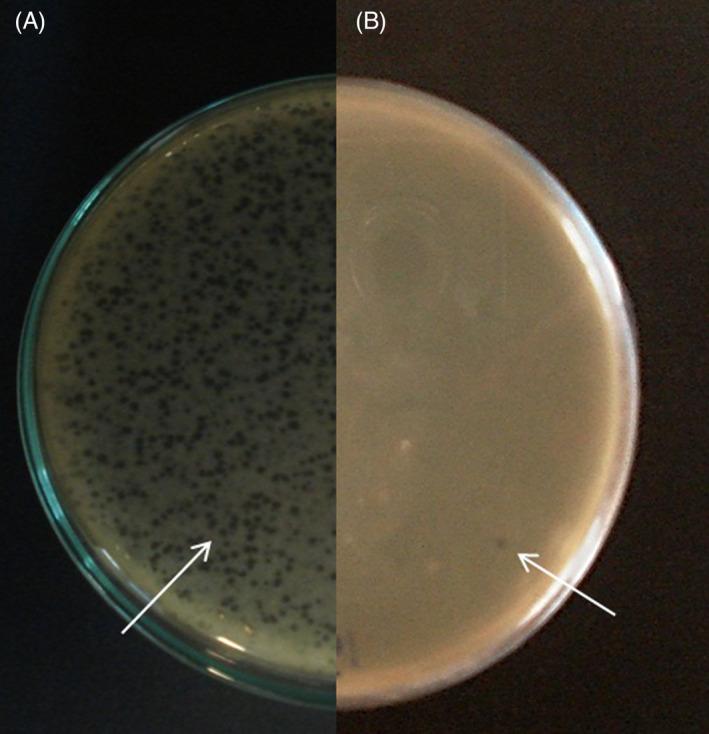
https://cdn.ncbi.nlm.nih.gov/pmc/blobs/45bf/9279972/2409b7a94a21/JCLA-36-e24497-g007.jpg

分离针对广泛耐药鲍曼不动杆菌感染的溶菌噬菌体及其在烧伤感染大鼠模型中的显著效果。
Isolation of a lytic bacteriophage against extensively drug-resistant Acinetobacter baumannii infections and its dramatic effect in rat model of burn infection.
机构信息
Department of Medical Laboratory Science, Faculty of Paramedicine, Arak University of Medical Sciences, Arak, Iran.
Molecular Research Center, Faculty of Medicine, Arak University of medical sciences, Arak, Iran.
出版信息
J Clin Lab Anal. 2022 Jul;36(7):e24497. doi: 10.1002/jcla.24497. Epub 2022 Jun 16.
OBJECTIVES
Acinetobacter Baumannii is an opportunistic nosocomial pathogen belonging to the Moraxellaceae family. The emergence of multidrug resistant strains of this pathogen caused many problems for hospitals and patients. The aim of the current study was to isolate, identify, and morphologically, physiologically, and in vivo analyze a new lytic bacteriophage targeting extensively drug-resistant (XDR) A. baumannii.
MATERIALS AND METHODS
Different wastewater samples were tested for isolation of lytic bacteriophage against 19 A. baumannii isolates obtained from patients hospitalized in a hospital in Arak, Iran, from January 2019 to March 2019. The phenotypic and genotypic characteristics of A. baumannii strains (resistance genes including: adeA, adeB, adeC, adeR, adeS, ISAba1, blaOXA-23, blaOXA-24) were analyzed. The isolated phage characteristics including adsorption time, pH and thermal stability, host range, one-step growth rate, electron microscopy examination, and therapeutic efficacy of the phage were also investigated. Therapeutic efficacy of the phage was evaluated in a rat model with burn infection of XDR A. baumannii. The lesion image was taken on different days after burning and infection induction and was compared with phage untreated lesions.
RESULTS
The results showed unique characteristics of the isolated phage (vB-AbauM-Arak1) including high specificity for Acinetobacter baumannii, stability at a relatively wide range of temperatures and pH values, short adsorption time, short latent period, and large burst size. In relation to the therapeutic efficacy of the phage, the lesion area decreased in phage-treated groups over 14 days than in those untreated, significantly (p < 0.05).
CONCLUSION
Our findings demonstrated that isolated lytic phage was able to eliminate burn infections caused by XDR A. baumannii in a rat model. So, it may be recommended as alternative options toward to developing a treatment for extensively drug resistant Acinetobacter infections.
目的
鲍曼不动杆菌是一种机会性医院获得性病原体,属于莫拉氏菌科。这种病原体的多药耐药株的出现给医院和患者带来了许多问题。本研究的目的是分离、鉴定和形态学、生理学以及体内分析针对广泛耐药(XDR)鲍曼不动杆菌的新型裂解噬菌体。
材料和方法
从 2019 年 1 月至 2019 年 3 月,伊朗阿拉克一家医院住院患者中获得的 19 株鲍曼不动杆菌分离物,检测不同废水样本以分离针对鲍曼不动杆菌的裂解噬菌体。分析鲍曼不动杆菌菌株的表型和基因型特征(耐药基因包括:adeA、adeB、adeC、adeR、adeS、ISAba1、blaOXA-23、blaOXA-24)。还研究了分离噬菌体的特性,包括吸附时间、pH 值和热稳定性、宿主范围、一步生长率、电子显微镜检查和噬菌体的治疗效果。在 XDR 鲍曼不动杆菌烧伤感染的大鼠模型中评估了噬菌体的治疗效果。在不同的天数后,对烧伤和感染诱导后的病变图像进行拍摄,并与未经噬菌体处理的病变进行比较。
结果
结果表明,分离的噬菌体(vB-AbauM-Arak1)具有独特的特性,包括对鲍曼不动杆菌的高度特异性、在较宽的温度和 pH 值范围内的稳定性、短吸附时间、短潜伏期和大爆发量。关于噬菌体的治疗效果,与未治疗组相比,噬菌体治疗组在 14 天内病变面积减小,差异有统计学意义(p<0.05)。
结论
我们的研究结果表明,分离的裂解噬菌体能够消除 XDR 鲍曼不动杆菌引起的大鼠烧伤感染。因此,它可以作为开发广泛耐药不动杆菌感染治疗方法的替代选择。